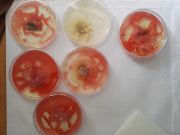
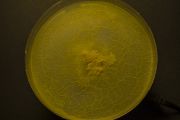

This special page shows all uploaded files.
| Date | Name | Thumbnail | Size | Description | Versions |
|---|---|---|---|---|---|
| 14:21, 21 October 2019 | Maze2.jpg (file) |  |
521 KB | File uploaded with MsUpload | 1 |
| 14:21, 21 October 2019 | Galeria9.jpg (file) |  |
634 KB | File uploaded with MsUpload | 1 |
| 14:21, 21 October 2019 | Galeria8.jpg (file) |  |
759 KB | File uploaded with MsUpload | 1 |
| 14:21, 21 October 2019 | Galeria7.jpg (file) |  |
566 KB | File uploaded with MsUpload | 1 |
| 14:21, 21 October 2019 | Galeria6.jpg (file) |  |
522 KB | File uploaded with MsUpload | 1 |
| 14:21, 21 October 2019 | Galeria10.jpg (file) |  |
519 KB | File uploaded with MsUpload | 1 |
| 14:21, 21 October 2019 | Galeria5.jpg (file) |  |
866 KB | File uploaded with MsUpload | 1 |
| 14:21, 21 October 2019 | Galeria4.jpg (file) |  |
559 KB | File uploaded with MsUpload | 1 |
| 14:21, 21 October 2019 | Galeria3.jpg (file) |  |
485 KB | File uploaded with MsUpload | 1 |
| 14:21, 21 October 2019 | Galeria2.jpg (file) |  |
639 KB | File uploaded with MsUpload | 1 |
| 14:21, 21 October 2019 | Galeria1.jpg (file) |  |
661 KB | File uploaded with MsUpload | 1 |
| 14:21, 21 October 2019 | Maze1.jpg (file) |  |
324 KB | File uploaded with MsUpload | 1 |
| 14:21, 21 October 2019 | Maze.jpeg (file) |  |
596 KB | File uploaded with MsUpload | 1 |
| 14:21, 21 October 2019 | Kittodos.jpg (file) |  |
740 KB | File uploaded with MsUpload | 1 |
| 13:59, 21 October 2019 | EXPERIMENTOS DESCRIPCION.pdf (file) | 1.82 MB | File uploaded with MsUpload | 1 | |
| 13:48, 21 October 2019 | Revvival.jpg (file) |  |
156 KB | File uploaded with MsUpload | 1 |
| 13:48, 21 October 2019 | Captura de pantalla 2019-06-19 a las 14.41.19.png (file) |  |
4.64 MB | File uploaded with MsUpload | 1 |
| 12:02, 21 October 2019 | Captura de pantalla 2019-06-19 a las 14.40.33.png (file) |  |
3.97 MB | File uploaded with MsUpload | 1 |
| 11:56, 21 October 2019 | Simbolo asociacion.jpg (file) |  |
132 KB | File uploaded with MsUpload | 1 |
| 11:22, 21 October 2019 | Captura de pantalla 2019-06-19 a las 14.38.54.png (file) |  |
1.01 MB | File uploaded with MsUpload | 1 |
| 11:22, 21 October 2019 | Captura de pantalla 2019-06-19 a las 14.34.57.png (file) |  |
5.29 MB | File uploaded with MsUpload | 1 |
| 11:22, 21 October 2019 | Captura de pantalla 2019-06-19 a las 14.35.29.png (file) |  |
7.02 MB | File uploaded with MsUpload | 1 |
| 10:51, 21 October 2019 | SimboloComunicacion1.jpg (file) |  |
100 KB | File uploaded with MsUpload | 1 |
| 10:51, 21 October 2019 | Captura de pantalla 2019-06-19 a las 14.34.20.png (file) |  |
2.61 MB | File uploaded with MsUpload | 1 |
| 10:51, 21 October 2019 | Captura de pantalla 2019-06-19 a las 14.34.03.png (file) |  |
2.65 MB | File uploaded with MsUpload | 1 |
| 10:45, 21 October 2019 | Captura de pantalla 2019-06-19 a las 14.33.47.png (file) |  |
6.32 MB | File uploaded with MsUpload | 1 |
| 14:04, 2 July 2019 | Physarum&I summaery2019.jpg (file) |  |
1.83 MB | File uploaded with MsUpload | 1 |
| 13:05, 8 May 2019 | C6SFkjZU4AAzoOC.jpg (file) |  |
18 KB | File uploaded with MsUpload | 1 |
| 10:46, 8 May 2019 | MG 0789.jpg (file) |  |
585 KB | File uploaded with MsUpload | 1 |
| 09:52, 8 May 2019 | 2cultivating physarum2.jpg (file) |  |
400 KB | File uploaded with MsUpload | 1 |
| 09:52, 8 May 2019 | 2cultivating physarum1.jpg (file) |  |
1.02 MB | File uploaded with MsUpload | 1 |
| 09:47, 8 May 2019 | 1cultivating physarum3.jpg (file) |  |
710 KB | File uploaded with MsUpload | 1 |
| 09:47, 8 May 2019 | 1cultivating physarum2.jpg (file) |  |
476 KB | File uploaded with MsUpload | 1 |
| 09:47, 8 May 2019 | 1cultivating physarum1.jpg (file) | |
607 KB | File uploaded with MsUpload | 1 |
| 11:58, 11 July 2018 | EXP92.jpg (file) |  |
395 KB | File uploaded with MsUpload | 1 |
| 14:46, 10 July 2018 | EXP9.jpg (file) |  |
315 KB | File uploaded with MsUpload | 1 |
| 14:44, 10 July 2018 | PyLED5.jpg (file) |  |
193 KB | File uploaded with MsUpload | 1 |
| 14:43, 10 July 2018 | PyLED6.jpg (file) |  |
170 KB | File uploaded with MsUpload | 1 |
| 14:38, 10 July 2018 | PyLED4.jpg (file) |  |
165 KB | File uploaded with MsUpload | 1 |
| 14:38, 10 July 2018 | PyLED3.jpg (file) | |
178 KB | File uploaded with MsUpload | 1 |
| 14:35, 10 July 2018 | PyLED2.jpg (file) |  |
165 KB | File uploaded with MsUpload | 1 |
| 14:34, 10 July 2018 | PyLED1.jpg (file) |  |
186 KB | File uploaded with MsUpload | 1 |
| 13:16, 9 July 2018 | EXP9LuzLEDenagartransparente.jpg (file) |  |
273 KB | File uploaded with MsUpload | 1 |
| 13:15, 9 July 2018 | EXP8luzynutrientestransparentes.jpg (file) |  |
638 KB | File uploaded with MsUpload | 1 |
| 13:11, 9 July 2018 | EXP8masfuertes2.jpg (file) |  |
810 KB | File uploaded with MsUpload | 1 |
| 13:08, 9 July 2018 | EXP8masfuertes.jpg (file) |  |
621 KB | File uploaded with MsUpload | 1 |
| 10:13, 4 July 2018 | EXPLUZ1.jpg (file) |  |
387 KB | File uploaded with MsUpload | 1 |
| 19:13, 3 July 2018 | SEPT13.jpg (file) |  |
138 KB | File uploaded with MsUpload | 1 |
| 19:13, 3 July 2018 | SEPT12.jpg (file) |  |
79 KB | File uploaded with MsUpload | 1 |
| 19:13, 3 July 2018 | SEPT11.jpg (file) |  |
69 KB | File uploaded with MsUpload | 1 |